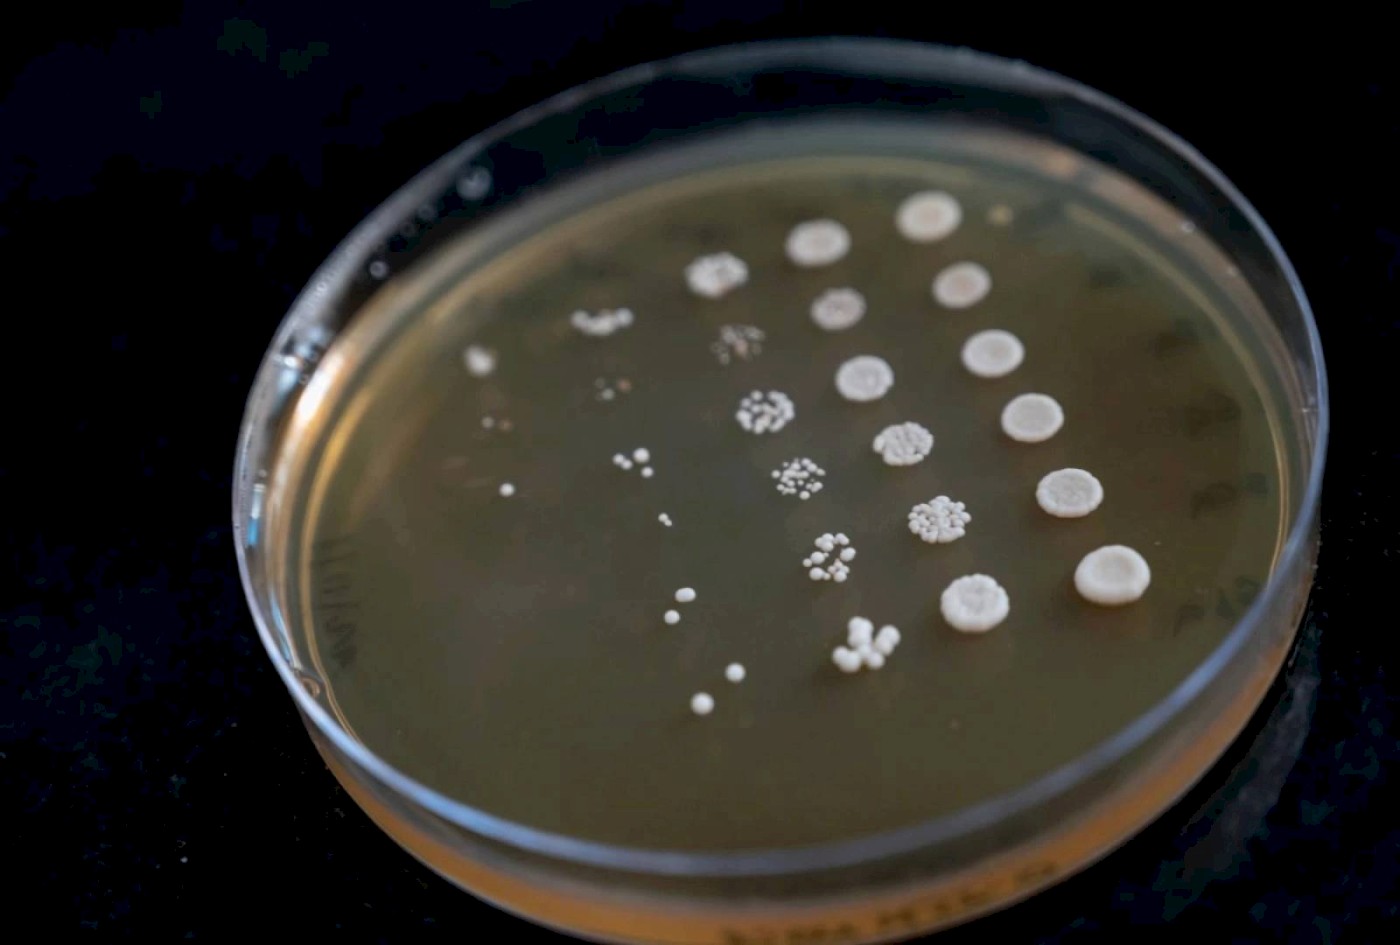

13 March 2023
Study Uncovers Role of Impaired Protein Complexes in Alleviating or Aggravating Hybrid Birth Defects
Speciation is one of the fundamental problems in the field of biology, being the source of ecological diversity on this planet. Understanding the consequences of climate change is essential, especially when we begin comprehending the mechanisms of incipient speciation. For example, there is recent evidence of emerging speciation barriers due to climate adaptation in Ficedula flycatchers1, insects such as butterflies, moths, apple maggot flies, and crickets2. A recent study by Krishna Swamy, Assistant Professor in the Biological and Life Sciences division, School of Arts and Sciences, Ahmedabad University, and his colleagues demonstrated a novel mechanism of speciation that can apply to all eukaryotic organisms, which include animals, plants, fungi, and protists. They successfully accounted for all the weak multiple genetic incompatibilities in introgressed hybrids of two closely related yeasts. Also, they discovered that the consequence of these incompatibilities is proteotoxic stress, as a novel driver of speciation. This work is published in Nature Communications. "Such weak incompatibilities can arise between populations due to changes in environmental or climatic conditions," the researchers say.
Professor Swamy explains the study: "When two populations of eukaryotic organisms cannot reproduce a fertile or a viable offspring, they are deemed two independent species. Genetic incompatibility, which leads to a failure in interactions between genes or proteins essential for the organism's survival, is one of the key drivers of eukaryotic speciation." The prevalent understanding of genetic incompatibility as a mechanism of evolution is limited to only two loci. However, multi-locus incompatibilities are commonly detected in both labs and the wild. "The multi-locus incompatibilities only demonstrate weak fitness defects when individual pairs of these loci are considered and have a severe fitness defect phenotype only when all the pairs are accounted for in an experiment, making it difficult to work with," he says.
The researchers demonstrated these complex incompatibilities using protein complexes, which are formed due to interactions between three or more proteins (e.g., ribosomes have 40 interacting proteins). They showed that when protein complexes are composed of proteins from two different species, they fail to successfully interact with each other, leading to the dissociation of all the proteins in the complex. Professor Swamy says, “Non-functional and misfolded proteins are usually degraded by proteasome, a cellular organelle responsible for maintaining protein homeostasis. In hybrids, proteasomes face a sudden avalanche of proteins marked for degradation and cause proteotoxic stress. In such a scenario, cells tend to conserve energy to fight the stress caused by proteotoxicity and truncate meiosis, i.e. sexual reproduction, and thus cause reproductive isolation between species (speciation).”
Implications of the Study
Understanding the mechanisms underlying speciation has diverse applications. For instance, cancer can be considered a species of cells in our body. The broad difference between species in the wild or nature and species (cancer cells) within a body is in how they procreate. In the wild, while eukaryotic procreate through sexual reproduction or meiosis, prokaryotic organisms multiply through asexual mitosis. Cancer, and several other diseases, also develop due to mitotic cell cycle defects. Professor Swamy explains, “When the cell cycle is defective, it has severe implications on genome stability and repair, causing high mutation rates, and in turn, causing aneuploidy among other phenotypes.”
In the study, the researchers have used introgressed hybrids of closely related yeast species that have almost all the genes common between them. These introgressed hybrids contain 14 to 15 chromosomes from one yeast and only one or two from its neighbouring donor yeast. This can emulate the level of genomic aberrations observed in mid-stage or late-stage cancer cells.
Interestingly, while the study primarily proposes a general mechanism of gene flow barrier between species, it also proposes potential mechanisms for how cancer cells can speciate or delineate from other normal cells of an organism. Professor Swamy says, “We have now performed evolution experiments using these introgressed hybrids, and we find the multi-chromosomal aneuploidy seen in almost all the evolved lineages (7/8) as a mechanism for accommodating foreign chromosomes. Chromosomal (multi) aneuploidy is a prominent phenotype observed during cancer progression. We thus feel that our findings can broaden our understanding of not only how ecological diversity emerges but also how diseases due to cell cycle defects, such as cancer, arise.”



